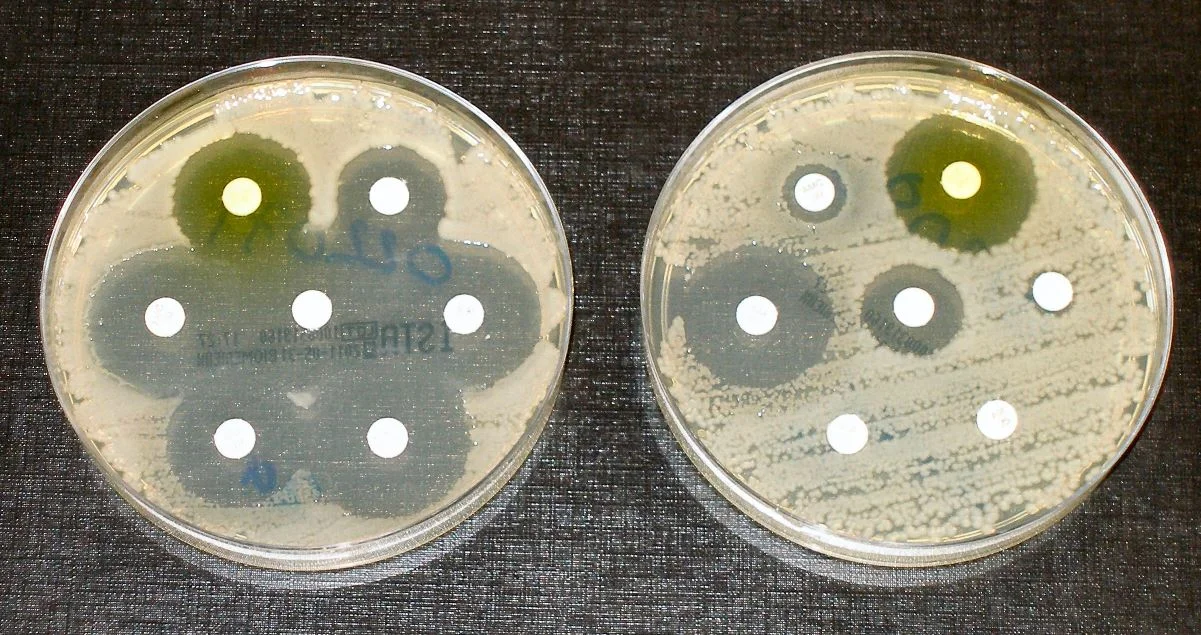

Subject: The search of new antibiotics in face of an increased amount of antibiotic resistant bacteria - Comments and suggestions are welcome! Don't hesitate and leave a comment on our comment section down below the article!
Antibiotics - Image Credit: Universal-Sci CC BY 4.0
A growing number of people worldwide are dying of infections because more and more bacteria are becoming resistant to antibiotics. New species are urgently needed. A promising resistance inhibitor is now in development by the research group of Nathaniel Martin, professor of Biological chemistry.
The figures are alarming: approximately 700,000 patients worldwide die each year from infections that could have been treated with antibiotics back in the 60s and 70s. However, today, many strains of bacteria have become increasingly resistant. The leading cause of this is the extensive and often incorrect use of antibiotics. Martin warns that by 2050, the number of annual deaths can rise to ten million if no serious investments and innovations are made.
Braking resistance
Together with his Leiden research group, he is working on a promising solution to combat the resistance mechanisms of bacteria. The researchers developed a new class of molecule inhibitors that block aggressive resistance enzymes. Laboratory studies show that conventional antibiotics, in combination with these new inhibitors, can kill resistant bacteria.
An antibiotic resistance tests. - Image Credit: Dr Graham Breads via Wikimedia Commons
In addition, professor Martin is using organic chemistry to structurally change conventional antibiotics so that they can work better and more safely. For example, his research group managed to make a specific type of antibiotic, the polymyxin class, (a class of antibiotics used for the treatment of Gram-negative bacterial infections) less toxic. Martin explains that polymyxins are essential antibiotics because they are among the few options that doctors still have to treat infections that barely respond to drugs.
Low on the priority list
Despite their crucial function, there are now only three major pharmaceutical manufacturers currently developing new antibiotics. The lion's share of antibiotics was discovered between the mid-40s and the early-70s. During this time, many natural antibiotics were found - (often antibacterial substances that occur in soil) that could be processed relatively easily into a medicine. Later on, partially because of the increasingly complicated development, the pharmaceutical industry started to focus more on combating other diseases such as cancer.
The impoverishment of the supply of antibiotics has significant consequences in light of the growing bacterial resistance to conventional antibiotics. Professor Martin calls on governments to use incentive measures to encourage manufacturers to develop new species of antibiotics.
Sources and further reading: Leiden University press release / Antibiotic / Antibiotic resistance
If you enjoy our selection of content please consider following Universal-Sci on social media: